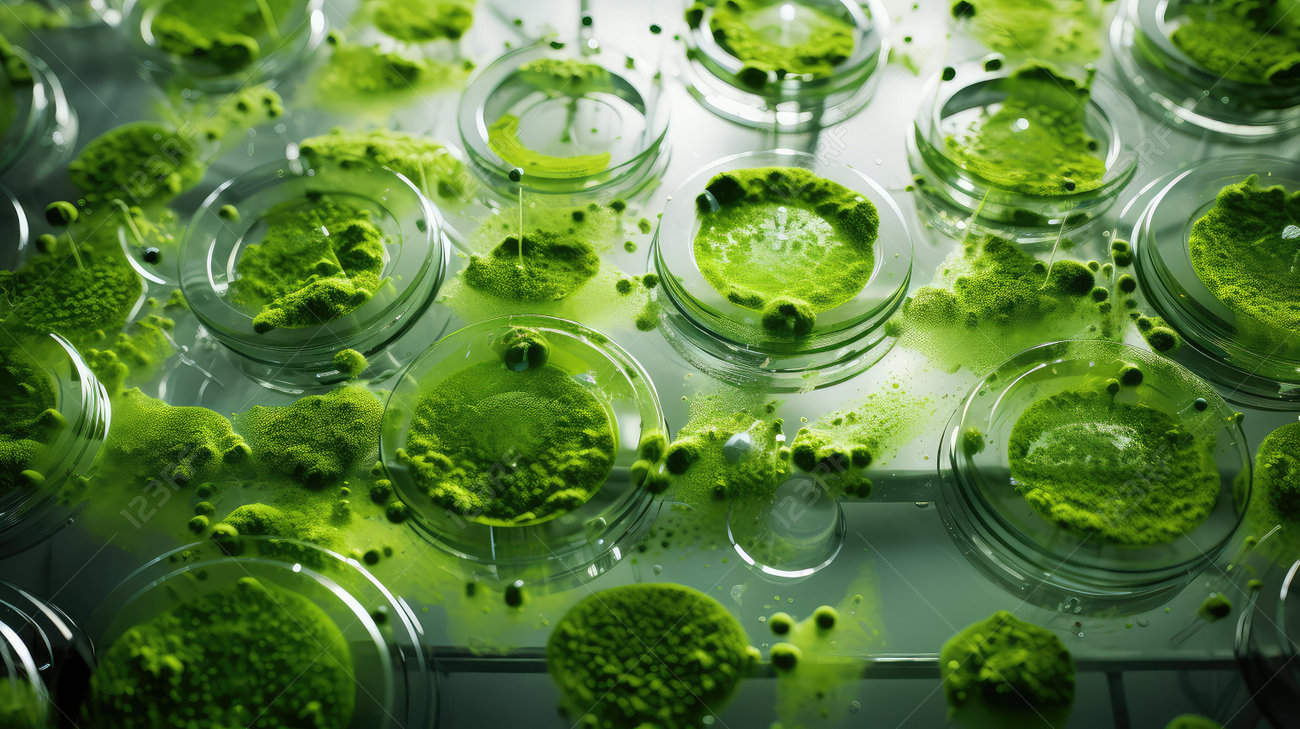
etiam-dictum-ipsum-a-felis

Download
Close
Автор:
id:
Ключевые слова:
algae, biofuel, clear, culture, energy, environment, floating, food, green, growth, health, illustration, image, importance, industries, laboratory, liquid, medium, micro, nutrition, organisms, photo, production, renewable, research, science, supplements, sustainable, technology, tiny, vibrant,





